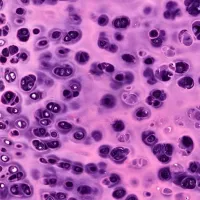
Product image

Designed for Pathology Minds Like Yours






Hyaline Cartilage Earrings
$57.00
Quantity
Explore more from this collection

© 2025 Digital Pathology Place - Aleksandra Zuraw, DMV, Ph.D., Dipl., ACVP
PO. Box 71, Fairfield, PA 17320, USA

Hyaline Cartilage Earrings
$57.00
Quantity

© 2025 Digital Pathology Place - Aleksandra Zuraw, DMV, Ph.D., Dipl., ACVP
PO. Box 71, Fairfield, PA 17320, USA